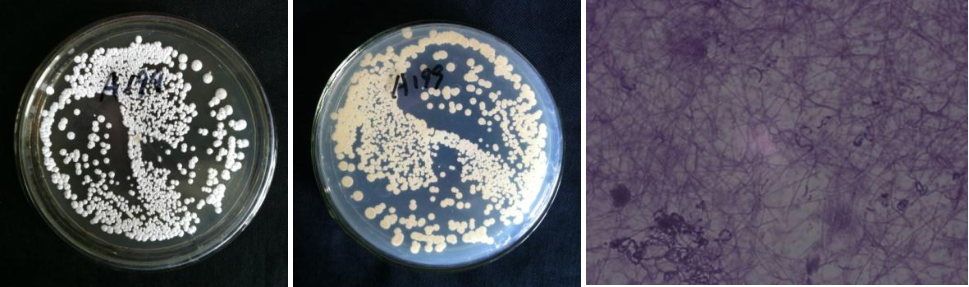

Loading...
| StrainNO | A199 |
| Classification | Streptomyces |
| 16s rDNA sequence | CACATGTCCGATCGAACGATGAACCCGCTTCGGTGGGGGATTAGTGGCGAACGGGTGAGTAACACGTGGGCAATCTGCCCTTCA CTCTGGGACAAGCCCGGGAAACGGGGTCTAATACCGGATACGACCACTTCAGGCATCTGATGGTGGTGGAAAGCTCCGGCGGTG AAGGATGAGCCCGCGGCCTATCAGCTTGTTGGTGAGGTAATGGCTCACCAAGGCGACGACGGGTAGCCGGCCTGAGAGGGCGAC CGGCCACACTGGGACTGAGACACGGCCCAAACTCCTACGGGAGGCAGCAGTGGGGAATATTGCACAATGGGCGAAAGCCTGATG CAGCGACGCCGCGTGAGGGATGACGGCCTTCGGGTTGTAAACCTCTTTCAGCAGGGAAGAAGCGAAAGTGACGGTACCTGCAGA AGAAGCGCCGGCTAACTACGTGCCAGCAGCCGCGGTAATACGTAGGGCGCAAGCGTTGTCCGGAATTATTGGGCGTAAAGAGCT CGTAGGCGGCTTGTCACGTCGGATGTGAAAGCCCGGGGCTTAACCCCGGGTCTGCATTCGATACGGGCAGGCTAGAGTGTGGTA GGGGAGATCGGAATTCCTGGTGTAGCGGTGAAATGCGCAGATATCAGGAGGAACACCGGTGGCGAAGGCGGATCTCTGGGCCAT TACTGACGCTGAGGAGCGAAAGCGTGGGGAGCGAACAGGATTAGATACCCTGGTAGTCCACGCCGTAAACGTTGGGAACTAGGT GTTGGCGACATTCCACGTCGTCGGTGCCGCAGCTAACGCATTAAGTTCCCCGCCTGGGGAGTACGGCCGCAAGGCTAAAACTCA AAGGAATTGACGGGGGCCCGCACAAGCAGCGGAGCATGTGGCTTAATTCGACGCAACGCGAAGAACCTTACCAAGGCTTGACAT ATACCGGAAACGGCCAGAGATGGTCGCCCCCTTGTGGTCGGTATACAGGTGGTGCATGGCTGTCGTCAGCTCGTGTCGTGAGAT GTTGGGTTAAGTCCCGCAACGAGCGCAACCCTTGTTCTGTGTTGCCAGCATGCCCTTCGGGGTGATGGGGACTCACAGGAGACT GCCGGGGTCAACTCGGAGGAAGGTGGGGACGACGTCAAGTCATCATGCCCCTTATGTCTTGGGCTGCACACGTGCTACAATGGC CGGTACAAAGAGCTGCGAAGCCGTGAGGCGGAGCGAATCTCAAAAAGCCGGTCTCAGTTCGGATTGGGGTCTGCAACTCGACCC CATGAAGTCGGAGTTGCTAGTAATCGCAGATCAGCATTGCTGCGGTGAATACGTTCCCGGGCCTTGTACACACCGCCCGTCACG TCACGAAAGTCGGTAACACCCGAAGCCGGTGGCCCAACCCCTTGTGGGAGGGAGCTGTCGAAGGTGGGACTGGCGATTGTTAGC AAGTCGTACC |
| Strain Morphology Photos | |
| Morphological Description | hyphae branch;apart;filaments long;spore filaments spiral or curved;spores larger and oval;spore pile milky white;back soy sauce yellow |